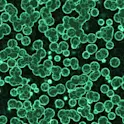

Earth science
04 Sep 2025
Biological ‘moonshot’ accelerates efforts to genetically map life on Earth
An unprecedented effort to sequence the genomes of 150,000 eukaryotic species through inclusive global collaboration.

Earth science
04 Sep 2025
An unprecedented effort to sequence the genomes of 150,000 eukaryotic species through inclusive global collaboration.
Young Minds
27 Sep 2022
We invite you to read the (forgotten) story of Esther Miriam Zimmer Lederberg

Featured news
08 May 2020
The exotic animal’s genome could point to possible treatment options for COVID-19 in humans: Frontiers in Immunology

Featured news
11 Feb 2019
Results from multi-institutional research collaboration show saliva-based RNA panel distinguishes children on autism spectrum from non-autistic peers; Frontiers in Genetics
Featured news
09 Jul 2018
The finding that a fungal parasite can quickly adapt to a population of genetically identical cyanobacteria helps explain why diversity in populations may be valuable for their preservation: Frontiers in Mirobiology

Life sciences
20 Feb 2018
Research reveals a novel potential drug target and offers new insights into the underlying biology of bipolar disorder: Frontiers in Behavioral Neuroscience

Life sciences
01 Feb 2018
Bacteria found in milk and beef may trigger the development of rheumatoid arthritis in people who are genetically at risk, finds a study in Frontiers in Cellular and Infection Microbiology

Featured news
15 Jan 2018
Research showing that viruses can transfer genes to organisms they are not known to infect may cast light on the ancient origins of viruses: Frontiers in Microbiology

Featured news
13 Nov 2017
A study in Frontiers in Medicine suggests that personal factors influence the chance of dental filling failure, and not the choice of filling material.

Life sciences
02 Nov 2017
The finding that DNA injected into damaged horse tendons can cure lameness has big implications for future of human medicine: Frontiers in Veterinary Science

Life sciences
27 Sep 2017
Researchers have identified new networks of related genes that may be involved in autism spectrum disorder, including those related to cancer, as described in Frontiers in Genetics.

Environment
26 Jul 2017
Scientists demonstrate that the indigenous knowledge of smallholder farming communities may yield genomic targets useful for wheat breeding.

Life sciences
26 May 2017
The Research Topic, Published in Frontiers in Oncology & Frontiers in Genetics aims to give a comprehensive overview of our current understanding of ubiquitin and SUMO pathways in all aspects of DDR

Life sciences
03 Apr 2017
Songbirds’ innovative behavioral adaptation in urban environments has fitness costs and benefits.

Neuroscience
12 Dec 2016
Researchers show a molecular mechanism that regulates memory specificity over time, and point to how understanding memory in honeybees could help us combat degenerative brain diseases
Get the latest research updates, subscribe to our newsletter